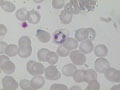

Hefen |

Hefen |

Pilze in Wasserprobe |

Pilze in Wasserprobe |

Pilze in Wasserprobe |

Nachweis Bioaktivität mit FDA |

Nachweis Bioaktivität mit FDA |

Assoziation von Bakterien an Metallhydroxiden |
Plasmodium |

Pilz REM-Aufnahme |

Pilz REM-Aufnahme |

MIC auf Nickel-Phosphor-Beschichtung |

Fluoreszenz-Aufnahme Coli |

Fluoreszenz-Aufnahme Bakterien auf Metallsubstrat |

Bacillus subtilus mit Cy3 markiert |